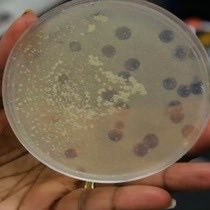

فاصل علمي؛ ملاحظين شي 🤔🤔
معرفة وجود البكتيروفيج، و اكتشاف البنسلين .. كله صدفة، نوعاً ما ..
ف خليك سَلِس في تفسير النتائج اللي تطلع معاكم في اللاب، يمكن اللي بيدك كنز .. او فعلاً .. مجرد تلوث ..
نرجع للبكتيروفيج ☕️
معرفة وجود البكتيروفيج، و اكتشاف البنسلين .. كله صدفة، نوعاً ما ..
ف خليك سَلِس في تفسير النتائج اللي تطلع معاكم في اللاب، يمكن اللي بيدك كنز .. او فعلاً .. مجرد تلوث ..
نرجع للبكتيروفيج ☕️
المهم، فريدريك، سوا اختبارات بسيطة و حاول عزل البيكتيريا اللي كانت في المتاطق الشفافة ( بكتيريا ميتة)، و عمل تخفيفات للفيج و لسا بيشوف انو بيقتل البكتيريا اللي نمت في الطبق فقط مو غيرها ..
طيب، وقتها ماكان معروف موضوع البكتيروفيج و الفيروسات اللي بتحلل البكتيريا، فقال التالي:
طيب، وقتها ماكان معروف موضوع البكتيروفيج و الفيروسات اللي بتحلل البكتيريا، فقال التالي:
١- يمكن انه هذا التحلل هوا مظهر غير عادي لدورة الحياة البكتيرية
٢- او انو البكتيريا نفسها انتجت إنزيمات و بذلك تسببت بتحللها
٣- او ممكن.. ممكن " فيروس مجهري للغاية"
و لكن الموارد المتاحة عنده ماساعدته على تأكيد او رفض اي من هذه الفرضيات، و ترك الموضوع في حاله .. و لا كبّره ..
٢- او انو البكتيريا نفسها انتجت إنزيمات و بذلك تسببت بتحللها
٣- او ممكن.. ممكن " فيروس مجهري للغاية"
و لكن الموارد المتاحة عنده ماساعدته على تأكيد او رفض اي من هذه الفرضيات، و ترك الموضوع في حاله .. و لا كبّره ..
الان، دايم افتكرو الاسم هذا دي هيريل
D’Herelle
لأنو ح يكون معانا و نتكلم عنه في مناسبات عديدة ☕️👏🏼
D’Herelle
لأنو ح يكون معانا و نتكلم عنه في مناسبات عديدة ☕️👏🏼
اوكي، اوكي، اوكي، الساينس موجود من فترات طويله .. حتى قبل دي هيريلدو فريدريك .. طيب ماكان فيه اي عالم من قبل انتبه لوجود الفيجات بما انها تعتبر من اكثر الكائنات الحية إنتشارا في الأرض ..
تتوقعو ممكن؟ بس تحت مسمى اخر، او ملاحظات اخرى .. بس مو بكتيروفيج ..
خلينا نشوف .. 🤓
تتوقعو ممكن؟ بس تحت مسمى اخر، او ملاحظات اخرى .. بس مو بكتيروفيج ..
خلينا نشوف .. 🤓
سبق و تكلمنا عن التجارب اللي ظهرت مع العلماء فيها قدرة الفيج لقتل و تحليل البكتيريا في اللاب و خارج اللاب ( الأنهار في الهند)
و هذا كان من عام ١٨٩٦ - الى دي هيريل في عام ١٩١٧ ..
نشوف السنوات اللي بعدها ايش صار معاهم .. ☕️
و هذا كان من عام ١٨٩٦ - الى دي هيريل في عام ١٩١٧ ..
نشوف السنوات اللي بعدها ايش صار معاهم .. ☕️
في عام ١٩١٩ ( سنتين بعد اكتشاف دي هيريل للبكتيروفيج و الاعلان عنه):
ظهرت اوائل افكار استخدامه للعلاج، و دي هيريل استخدم الفيج لعلاج حالات الزحار في الأطفال ( فرنسا).
الفيج عزله من براز الجنود في معهد Pasture
وقتها ما نشر دا الشي، و فضل انو يعمل دراسات مكثفه على هذه الفيجات.
ظهرت اوائل افكار استخدامه للعلاج، و دي هيريل استخدم الفيج لعلاج حالات الزحار في الأطفال ( فرنسا).
الفيج عزله من براز الجنود في معهد Pasture
وقتها ما نشر دا الشي، و فضل انو يعمل دراسات مكثفه على هذه الفيجات.
في عام ١٩٢٠ م
اصبح فيه توسع كبير لتجربة العلاج بالبكتيروفيج لأمراض عدة مثل الكوليرا، الزحار، الطاعون، التهاب الملتحمة و العدوى البكتيرية اللي تصيب الجلد ..
اصبح فيه توسع كبير لتجربة العلاج بالبكتيروفيج لأمراض عدة مثل الكوليرا، الزحار، الطاعون، التهاب الملتحمة و العدوى البكتيرية اللي تصيب الجلد ..
و لكن، لأن العلم بيتطور و الإكتشافات بتزيد ..
بعد ٩ سنوات و في عام ١٩٢٩م
فليمنغ تكلم عن البنسلين لأول مرة ..
( المضاد الحيوي) ..
و نشره في المجلة البريطانية لعلم الأمراض التجريبي ..
المجتمع العلمي تحمس معاه وقتها، بس فليمنغ وقتها واجه صعوبة في عزل البنسلين بكمية كبيرة..
بعد ٩ سنوات و في عام ١٩٢٩م
فليمنغ تكلم عن البنسلين لأول مرة ..
( المضاد الحيوي) ..
و نشره في المجلة البريطانية لعلم الأمراض التجريبي ..
المجتمع العلمي تحمس معاه وقتها، بس فليمنغ وقتها واجه صعوبة في عزل البنسلين بكمية كبيرة..
نرجع للعلاج بالفيج شويتين:
عام ١٩٣٣ و ١٩٣٤ يعني تقريبا بعد ١٣ سنه من استخدام الفيج كعلاج،
بدأت تطلع مراجعات علمية نقدية لإستخدام الفيج كعلاج و هذا الشي كان بسبب نقص بعض الشروط العلمية المطلوبة مثل اثبات فعاليته ( يحتاج لدراسة)، وجود الكنترول ( لقياس تأثير الفيج فعلا)..الخ
عام ١٩٣٣ و ١٩٣٤ يعني تقريبا بعد ١٣ سنه من استخدام الفيج كعلاج،
بدأت تطلع مراجعات علمية نقدية لإستخدام الفيج كعلاج و هذا الشي كان بسبب نقص بعض الشروط العلمية المطلوبة مثل اثبات فعاليته ( يحتاج لدراسة)، وجود الكنترول ( لقياس تأثير الفيج فعلا)..الخ
جاري تحميل الاقتراحات...